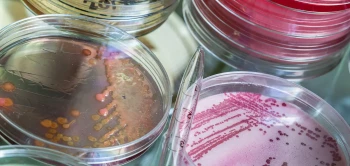

Dit is een van de vele vragen die we hebben over het coronavirus. Want opvallend is het wel: wereldwijd overlijden twee tot drie keer meer mannen dan vrouwen aan het coronavirus. BPRC-wetenschappers bogen zich ook over dit opmerkelijke feit en publiceerden een hypothese.
Op genetisch niveau bestudeerden ze verschillen tussen mannen en vrouwen die mogelijk een rol kunnen spelen. Zo weten we al dat het virus een bepaald eiwit (de ACE2 receptor) nodig heeft om ons lichaam binnen te dringen. Mocht dit eiwit verschillen tussen man en vrouw dan zou dit een mogelijke verklaring kunnen zijn. Echter…eerder onderzoek wees uit dat dit waarschijnlijk niet het geval is.
Herkenning van ziekteverwekkers
Een andere mogelijkheid is dat het immuunsysteem van vrouwen anders reageert dan mannen. Het immuunsysteem heeft verschillende mogelijkheden om ziekteverwekkers te herkennen en in actie te komen. In de eerste herkenning van ziekteverwekkers speelt een bepaalde familie van eiwitten, de zogenaamde ‘Toll-like receptoren’ (TLR), een essentiële rol. Verschillende TLR kunnen verschillende onderdelen van ziekteverwekkers herkennen en vervolgens het immuunsysteem aanzetten tot actie. De vraag is dus, welke TLR kan het coronavirus herkennen?
Herkenning van het coronavirus
We weten van vier TLR-eiwitten dat zij stukjes virus kunnen herkennen. De genetische code van twee van de vier TLR-eiwitten, TLR7 en 8, is vastgelegd in het X-chromosoom. Vrouwen hebben twee van deze X-chromosomen en mannen slechts een. Hoewel normaal gesproken een van beide X-chromosomen inactief is, ontwijken de TLR7- en waarschijnlijk ook de TLR8-genen dit. En dus hebben vrouwen meer van deze TLR-eiwitten dan mannen.
In de long
Verder weten we dat in de long, de plek waar het coronavirus veel schade aanbrengt, veel immuuncellen met TLR7 en TLR8 aanwezig zijn. Misschien kunnen vrouwen het coronavirus daar beter en dus effectiever herkennen doordat ze meer TLR7 en -8 hebben. Teveel van deze eiwitten kan helaas ook averechts werken. Dan valt het immuunsysteem het eigen lichaam aan en ontstaat er een auto-immuunziekte. Een goede balans is dus essentieel.
Nog ingewikkelder
Om het nog ingewikkelder te maken: TLR7 en -8 zijn op de X-chromosomen ook nog eens per individu in verschillende aantallen kopieën aanwezig. Dit kan dus ook een verschil in immuunreactie op het coronavirus opleveren. De onderzoekers bevelen dan ook aan om in coronapatiënten de TLR7 en -8 genen in kaart te brengen. Meer kennis hierover is belangrijk, want hiermee kunnen we bepalen hoe een toekomstig vaccin het beste kan worden ingezet.